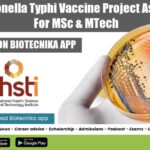
THSTI Jobs 2022

Home Search
microbiology - search results
If you're not happy with the results, please do another search
Biotecnika Times Newsletter 05.04.2022 TIFR Recruitment, IISER Summer Internship, Bose
Biotecnika Times - TIFR Recruitment, IISER Summer Internship, Bose
CUET UG 2022 Online Application Form Update – Check Latest CUET UG 2022 Information
CUET UG 2022...
IISER Tirupati PhD Admission 2022 August – Applications Invited
IISER Tirupati PhD 2022 Admission August - Applications Invited
The official announcement for the IISER Tirupati PhD Biology Program Admissions August 2022 has been made...
Biotecnika Times Newsletter 04.04.2022 Google Rs 37 Lakh Fellowship, Govt BCIL Rs. 75,000 pm
Biotecnika Times - Google Rs 37 Lakh Fellowship, Govt BCIL Rs. 75,000
Government BCIL Jobs With Up to Rs. 75,000 pm Salary For Biotech &...
AIIMS Rae Bareli Research Assistant Recruitment, Applications Invited
AIIMS Rae Bareli Job - Research Assistant Recruitment, Applications Invited
AIIMS Rae Bareli Job - Research Assistant Recruitment, Applications Invited. MSc Microbiology / Virology...
THSTI Salmonella Typhi Vaccine Project Associate Job For MSc & MTech
THSTI Jobs 2022 - Project Associate Vacancy For MSc & MTech
THSTI Jobs 2022 - Project Associate Vacancy For MSc & MTech. Life Sciences/ Biotechnology/...
Govt RGCB Cancer Stem Cells Project Research Fellow Recruitment
RGCB Research Job - Life Sciences Apply Online
RGCB Research Job - Life Sciences Apply Online. Rajiv Gandhi Centre for Biotech, Biochem, Botany, zoology, life...
Biotecnika Times 01.04.2022 Newsletter Delhi Govt ILBS Job, DRDO-INMAS Life Sciences Job
Biotecnika Times - Delhi Govt ILBS Job, DRDO-INMAS Life Sciences Job
Govt of Delhi ILBS Hiring Research Associate Job For Life Sciences, Biotech & Immunology
Delhi...
THSTI Project Jobs For MSc & PhD Life Sciences – Attend Walk-In-Interview
THSTI Research Vacancies 2022 - MSc & PhD Life Sciences Walk-In
THSTI Research Vacancies 2022 - MSc & PhD Life Sciences Walk-In. THSTI Jobs 2022....
Biotecnika Times 30.03.2022 Newsletter Govt Silk Board Jobs, Govt APEDA Hiring, CBMR
Biotecnika Times - Govt Silk Board Jobs, Govt APEDA Hiring, CBMR
Govt Central Sericultural Research & Training Institute Research Fellow Recruitment
Silk Board Jobs 2022 –...
SERB Funded Govt Institute of Life Sciences Junior Research Fellow Recruitment
ILS JRF Job Post - Life Sciences Research Fellow Opening
ILS JRF Job Post - Life Sciences Research Fellow Opening. Institute of Life Sciences Junior...
ICMR-NIIH Research Fellow Jobs For Life Sciences, Apply Online
ICMR-NIIH Research Fellow Jobs For Life Sciences, Apply Online
ICMR-NIIH Research Fellow Jobs For Life Sciences, Apply Online. NIIH Jobs 2022. ICMR-National Institute of Immunohaematology...
JNCASR Research Fellow Jobs For Life Sciences, Applications Invited
JNCASR Research Fellow Jobs For Life Sciences, Applications Invited
JNCASR Research Fellow Jobs For Life Sciences, Applications Invited. Research Fellow positions at JNCASR. JNCASR Research...
Govt Central Sericultural Research & Training Institute Research Fellow Recruitment
Silk Board Jobs 2022 - CSRTI Mysore JRF Job Opening
Silk Board Jobs 2022 - CSRTI Mysore JRF Job Opening. MSc Biotech/ Mol Bio/ Microbiology/...
Biotecnika Times 30.03.2022 Newsletter IISc Recruitment, IISc Internship, ICMR-DHR 65
Biotecnika Times - IISc Recruitment, IISc Internship, ICMR-DHR 65
IISc Project Associate Job In Dept. of Microbiology & Cell Biology
IISc Project Associate Job In...
AIIMS Delhi JRF Vacancy Available For Life Sciences – Check Details
AIIMS Delhi JRF Post Available For Life Sciences - Check Details
AIIMS Delhi JRF Post Available For Life Sciences - Check Details. JRF job opening...